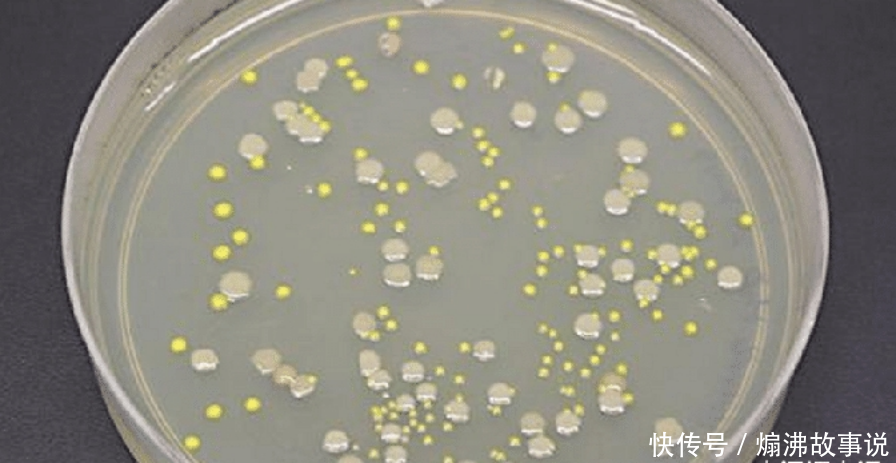

友情提示
本站部分转载文章,皆来自互联网,仅供参考及分享,并不用于任何商业用途;版权归原作者所有,如涉及作品内容、版权和其他问题,请与本网联系,我们将在第一时间删除内容!
联系邮箱:1042463605@qq.com
专家在南极冰川下发现未知生物,并且拥有几十万年的寿命,究竟是怎么回事?
50
0
相关文章
近七日浏览最多
最新文章
标签云
邮轮
南极
舱位
俞敏洪
新东方
房地产
麦当劳
布莱恩
美国军方
生态平衡
外星文明
保持沉默
希特勒
全球变暖
外星人
平行宇宙
美国政府
英法德
冰雪世界
恐龙
海豹
斯诺登
蓝鲸
野生动物
天文学家
星系
宇宙
中国长城
科学家
土卫六
木卫二
北极
史前文明
探险者
无主之地
哥斯拉
史前
陨石
行星
纳粹
基地
日本
俄罗斯
北斗
美国
月球
卫星
达尔文
探测器
nasa
理查德
自由飞翔
微生物
新物种
航天员
空间站
地球
蛋白
科学
院士
酵母菌
纪录片
生物制造
中国中央电视台
北京青年
火星探测器
火星
粘锅
调味料
宇航员
太空
葡萄干
黄曲霉菌
黄曲霉素
华南虎
头皮
口腔
白酒
王家卫
蜂蜜
肥料
英国
马铃薯
聊天记录
剩饭剩菜
隔夜菜
是真的吗
动物世界
古特雷斯
气候变化
热浪
全球气候变暖
北半球
杭州
睡眠质量
糖尿病酮症酸中毒
皮肤瘙痒
血糖监测
血糖控制
糖尿病患者
糖尿病
青藏高原
寄生虫
农业生产
尼泊尔
阿拉斯加
狐狸
新疆
中国传统文化
中国气象局
重庆
蜘蛛蟹
鲨鱼
我们的生活
雪豹
藏獒
食肉动物
甲烷
新西兰
海豚
琳达
中国文化
中国龙
鲸鱼
哺乳动物
哥白尼
不良习惯
睡眠时间
冠心病
光照
心理健康
大象
云南